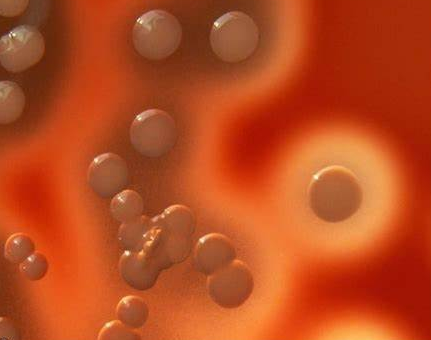
ͼƬ2.png

博文
细菌真菌检测-合规高效精准检测
|
生物医药产业的质量安全,始于微生物的严格管控。药品、生物制品、细胞基因治疗产品等在生产、研发、放行全流程中,易受金黄色葡萄球菌、铜绿假单胞菌、白色念珠菌等致病性细菌、真菌污染,不仅会破坏产品有效成分、导致产品失效,更可能引发严重的临床感染,威胁用药安全。与此同时,《中国药典2025版》等国内外法规对微生物检测提出了更高要求,既鼓励快速微生物检测技术(RMM)的应用,又明确了替代方法的合规验证标准。
翼和生物细菌真菌快检试剂盒的研发、生产与验证全程紧扣国内外最新法规要求,针对药典明确的金黄色葡萄球菌、铜绿假单胞菌、枯草芽孢杆菌、白色念珠菌、黑曲霉、大肠埃希菌、乙型副伤寒沙门菌、生孢梭菌8种参数验证所需菌种,实现精准靶向检测;产品完全符合《中国药典2025版》1101无菌检查法、9406细胞类制品微生物检查指导原则等要求,通过方法学验证,可作为传统培养法的合规替代方法,适用于药品、生物制品、细胞基因治疗产品、制药用水等的生产过程质量控制、终产品放行检测,同时满足科研机构的微生物检测研究需求。

此外,试剂盒适配法规对快速微生物检测的技术要求,相较于传统培养法动辄数天的检测周期,实现数小时内出结果,大幅提升检测效率,助力企业实现生产过程的实时监控与产品快速放行,尤其适用于短效期生物制品的质量管控。
核心技术创新,精准高效攻克检测痛点
传统微生物检测以培养法为核心,存在检测周期长、灵敏度低、操作繁琐等痛点,而普通核酸检测试剂盒又面临引物特异性不足、检测稳定性差、样本干扰大等问题。翼和生物依托多年分子检测技术积淀,对荧光定量PCR技术进行深度优化,打造出兼具高特异性、高灵敏度、高稳定性的细菌真菌快检技术体系,攻克行业检测痛点。
靶向引物设计,实现菌种精准区分
针对8种目标菌株的特异性基因序列,设计专属引物与探针,实现对不同菌株的精准靶向扩增,无交叉反应,即使是亲缘关系相近的菌株也能有效区分,解决了传统检测中菌种鉴定难、易出现假阳性的问题,检测特异性达100%。

超高检测灵敏度,低浓度污染精准捕捉
试剂盒经严苛的性能验证,对各目标菌株的检测限可达10¹CFU/ml,即使样本中存在极低浓度的微生物污染,也能精准捕捉;通过10倍浓度梯度稀释验证,各菌株扩增效率均保持在88.51%-99.68%,标准曲线相关系数R²≥0.99,线性关系良好,检测结果精准可靠,实现对微量污染的早发现、早防控。

多重体系优化,保障检测稳定性
试剂盒采用多重荧光定量PCR体系,可实现多菌株联检与内参同步检测,内参全程监控实验流程,有效排除样本提取、扩增过程中的人为误差与样本抑制因素,避免假阴性结果;经5次以上-20℃与37℃极端温度反复冻融验证,试剂盒检测结果基本一致,性能稳定,可长期储存;同时适配ABI、Roche、Bio-Rad、宏石等主流品牌的qPCR仪,无需额外更换实验设备,适配企业现有检测体系。
https://blog.sciencenet.cn/blog-3140696-1527136.html
上一篇:疫苗里的“微量DNA”,Vero细胞残留DNA检测
下一篇:拷贝数变异(CNV)的精准验证:检测的“技术困境”